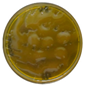
Fermentation 11 00498 i001 Fermentation 11 00498 i001

Screening Sourdough Starter Cultures from Yeast and Lactic Acid Bacteria Isolated from Mexican Cocoa Mucilage and Coffee Pulp for Bread Quality Improvement
Abstract
1. Introduction
2. Materials and Methods
2.1. Chemicals, Enzymes, and Broths
2.2. Microorganisms and Growth Conditions
2.3. Molecular Indentification of Yeast and LAB Strains from Cocoa Fermentation
2.4. Enzymatic Activities of Yeast and LAB Isolates
2.4.1. Phytase Activity
2.4.2. Proteolytic Activity
2.4.3. Amylolytic Activity
2.5. Gas Production by Yeast
2.6. Lactic Acid Production Capacity
Determination of the Lactic Acid Concentration
2.7. Screening LAB Exopolysaccharide (EPS) Production
2.8. Sourdough Elaboration and Breadmaking
2.9. Bread Quality
2.9.1. Crumb Firmness Analysis
2.9.2. Crumb Structure by Image Analysis
2.10. Statistical Analysis
3. Results and Discussion
3.1. Microorganisms Identified in Cocoa Mucilage
3.2. Screening and Selection of Yeast and LAB Strains
3.2.1. Quantitative Halo-Based Enzymatic Screening of Strains from Cocoa Mucilage
3.2.2. Dough Fermentability by Yeast Isolated from Cocoa Mucilage and Coffee Pulp
3.2.3. Determination of Lactic Acid Production by LAB from Cocoa Mucilage and Coffee Pulp
3.2.4. Exopolysaccharide (EPS) Production by LAB from Cocoa Mucilage and Coffee Pulp
3.3. Sourdough Bread Quality
4. Conclusions
Author Contributions
Funding
Institutional Review Board Statement
Informed Consent Statement
Data Availability Statement
Acknowledgments
Conflicts of Interest
Abbreviations
| LAB | Lactic acid bacteria |
| EPS | Exopolysaccharide |
| AP | Alveolar porosity |
| AR | Alveolar regularity |
| CI | Circularity index |
References
- Suo, B.; Chen, X.; Wang, Y. Recent research advances of lactic acid bacteria in sourdough: Origin, diversity, and function. Curr. Opin. Food Sci. 2021, 37, 66–75. [Google Scholar] [CrossRef]
- Arora, K.; Ameur, H.; Polo, A.; Di Cagno, R.; Rizzello, C.G.; Gobbetti, M. Thirty years of knowledge on sourdough fermentation: A systematic review. Trends Food Sci. Technol. 2021, 108, 71–83. [Google Scholar] [CrossRef]
- Hernández-Parada, N.; González-Ríos, O.; Suárez-Quiroz, M.L.; Hernández-Estrada, Z.J.; Figueroa-Hernández, C.Y.; Figueroa-Cárdenas, J.D.D.; Rayas-Duarte, P.; Figueroa-Espinoza, M.C. Exploiting the native microorganisms from different food matrices to formulate starter cultures for sourdough bread production. Microorganisms 2023, 11, 109. [Google Scholar] [CrossRef]
- Calvert, M.D.; Madden, A.A.; Nichols, L.M.; Haddad, N.M.; Lahne, J.; Dunn, R.R.; McKenney, E.A. A review of sourdough starters: Ecology, practices, and sensory quality with applications for baking and recommendations for future research. PeerJ 2021, 9, e10972. [Google Scholar] [CrossRef] [PubMed]
- Corsetti, A.; Gänzle, M. Technology of sourdough fermentation and sourdough applications. In Handbook on Sourdough Biotechnology; Springer: Boston, MA, USA, 2013; pp. 1–298. [Google Scholar] [CrossRef]
- Ogunsakin, A.O.; Vanajakshi, V.; Anu-Appaiah, K.A.; Vijayendra, S.V.N.; Walde, S.G.; Banwo, K.; Sanni, A.I.; Prabhasankar, P. Evaluation of functionally important lactic acid bacteria and yeasts from Nigerian sorghum as starter cultures for gluten-free sourdough preparation. LWT 2017, 82, 326–334. [Google Scholar] [CrossRef]
- Shen, J.; Shi, K.; Dong, H.; Yang, K.; Lu, Z.; Lu, F.; Wang, P. Screening of sourdough starter strains and improvements in the quality of whole wheat steamed bread. Molecules 2022, 27, 3510. [Google Scholar] [CrossRef] [PubMed]
- Lim, S.B.; Tingirikari, J.M.R.; Seo, J.S.; Li, L.; Shim, S.; Seo, J.H.; Han, N.S. Isolation of lactic acid bacteria starters from Jeung-Pyun for sourdough fermentation. Food Sci. Biotechnol. 2018, 27, 73–78. [Google Scholar] [CrossRef] [PubMed]
- Mohd Roby, B.H.; Muhialdin, B.J.; Abadl, M.M.T.; Mat Nor, N.A.; Marzlan, A.A.; Lim, S.A.H.; Mustapha, N.A.; Meor Hussin, A.S. Physical properties, storage stability, and consumer acceptability for sourdough bread produced using encapsulated Kombucha sourdough starter culture. J. Food Sci. 2020, 85, 2286–2295. [Google Scholar] [CrossRef]
- Yu, Y.; Wang, L.; Qian, H.; Zhang, H.; Qi, X. Contribution of spontaneously-fermented sourdoughs with pear and navel orange for the bread-making. LWT 2018, 89, 336–343. [Google Scholar] [CrossRef]
- Nionelli, L.; Montemurro, M.; Pontonio, E.; Verni, M.; Gobbetti, M.; Rizzello, C.G. Pro-technological and functional characterization of lactic acid bacteria to be used as starters for hemp (Cannabis sativa L.) sourdough fermentation and wheat bread fortification. Int. J. Food Microbiol. 2018, 279, 14–25. [Google Scholar] [CrossRef]
- Păcularu-Burada, B.; Ceoromila (Cantaragiu), A.-M.; Vasile, M.A.; Bahrim, G.-E. Novel insights into different kefir grains usefulness as valuable multiple starter cultures to achieve bioactive gluten-free sourdoughs. LWT 2022, 165, 113670. [Google Scholar] [CrossRef]
- Limbad, M.; Maddox, N.G.; Hamid, N.; Kantono, K. Sensory and physicochemical characterization of sourdough bread prepared with a coconut water kefir starter. Foods 2020, 9, 1165. [Google Scholar] [CrossRef]
- Graça, C.; Edelmann, M.; Raymundo, A.; Sousa, I.; Coda, R.; Sontag-Strohm, T.; Huang, X. Yoghurt as a starter in sourdough fermentation to improve the technological and functional properties of sourdough-wheat bread. J. Funct. Foods 2022, 88, 104877. [Google Scholar] [CrossRef]
- Ripari, V.; Gänzle, M.G.; Berardi, E. Evolution of sourdough microbiota in spontaneous sourdoughs started with different plant materials. Int. J. Food Microbiol. 2016, 232, 35–42. [Google Scholar] [CrossRef]
- Schwan, R.; Silva, C.; Batista, L. Coffee fermentation. In Handbook of Plant-Based Fermented Food and Beverage Technology, 2nd ed.; Taylor & Francis: Boca Raton, FL, USA, 2012; pp. 677–690. [Google Scholar] [CrossRef]
- Nigam, P.S.; Singh, A. Cocoa and coffee fermentations. In Encyclopedia of Food Microbiology, 2nd ed.; Elsevier Inc.: Oxford, UK, 2014; pp. 485–492. ISBN 9780123847331. [Google Scholar]
- Haile, M.; Kang, W.H. The role of microbes in coffee fermentation and their impact on coffee quality. J. Food Qual. 2019, 2019, 4836709. [Google Scholar] [CrossRef]
- Bae, H.M.; Haile, M.; Kang, W.H. Evaluation of antioxidant, organic acid, and volatile compounds in coffee pulp wine fermented with native yeasts isolated from coffee cherries. Food Sci. Technol. Int. 2022, 28, 716–727. [Google Scholar] [CrossRef] [PubMed]
- Roussos, S.; de los Angeles Aquiahuatl, M.; del Refugio Trejo-Hernández, M.; Gaime-Perraud, I.; Favela, E.; Raimbault, G.; Viniegra-González, G. Biotechnological management of coffee pulp—Isolation, screening, characterization, selection of caffeine-degrading fungi and natural microflora present in coffee pulp and husk. Appl. Microbiol. Biotechnol. 1995, 42, 756–762. [Google Scholar] [CrossRef]
- Arellano-González, M.A.; Ramírez-Coronel, M.A.; Torres-Mancera, M.T.; Pérez-Morales, G.G.; Saucedo-Castañeda, G. Antioxidant activity of fermented and nonfermented coffee (Coffea arabica) pulp extracts. Food Technol. Biotechnol. 2011, 49, 374–378. [Google Scholar]
- Machuca-Guevara, J.I.; Suárez-Peña, E.A.; Darricau, E.M.; Mialhe-Matonnier, E.L. Molecular characterization of microorganisms during cocoa-bean fermentation process (Theobroma cacao). Rev. Peru. Biol. 2019, 26, 535–542. [Google Scholar] [CrossRef]
- Sarbu, I.; Csutak, O. The microbiology of cocoa fermentation. In Caffeinated and Cocoa Based Beverages, Volume 8: The Science of Beverages; Preedy, V.R., Ed.; Elsevier: London, UK, 2019; pp. 423–446. ISBN 9780128158647. [Google Scholar] [CrossRef]
- Cempaka, L.; Aliwarga, L.; Purwo, S.; Kresnowati, M.T.A.P. Dynamics of cocoa bean pulp degradation during cocoa bean fermentation: Effects of yeast starter culture addition. J. Math. Fund. Sci. 2014, 46, 14–25. [Google Scholar] [CrossRef]
- Lau, S.W.; Chong, A.Q.; Chin, N.L.; Talib, R.A.; Basha, R.K. Sourdough microbiome comparison and benefits. Microorganisms 2021, 9, 1355. [Google Scholar] [CrossRef]
- De Vuyst, L.; Neysens, P. The sourdough microflora: Biodiversity and metabolic interactions. Trends Food Sci. Technol. 2005, 16, 43–56. [Google Scholar] [CrossRef]
- Landis, E.A.; Oliverio, A.M.; McKenney, E.A.; Nichols, L.M.; Kfoury, N.; Biango-Daniels, M.; Shell, L.K.; Madden, A.A.; Shapiro, L.; Sakunala, S.; et al. The diversity and function of sourdough starter microbiomes. eLife 2021, 10, e61644. [Google Scholar] [CrossRef]
- Lhomme, E.; Urien, C.; Legrand, J.; Dousset, X.; Onno, B.; Sicard, D. Sourdough microbial community dynamics: An analysis during French organic bread-making processes. Food Microbiol. 2016, 53, 41–50. [Google Scholar] [CrossRef]
- Von Gastrow, L.; Amelot, R.; Segond, D.; Guézennec, S.; Valence, F.; Sicard, D. Microbial community dispersal in sourdough. bioRxiv 2021. [Google Scholar] [CrossRef]
- Cervantes-Ilizaliturri, A.-A. Aislamiento y Caracterización de Bacterias Ácido-Lácticas Aisladas del Cacao con Capacidad Antifúngica. Master’s Thesis, Instituto Tecnológico de Veracruz, Veracruz, México, 2020. [Google Scholar]
- Hernández-Parada, N. Selección de Levaduras y Bacterias Autóctonas de la Fermentación de Cacao Mexicano Para la Formulación de Cultivos Iniciadores. Master’s Thesis, Instituto Tecnológico de Veracruz, Veracruz, México, 2021. [Google Scholar]
- Romero-Isaza, S.P. Aislamiento y Caracterización de Levaduras Autóctonas del Café Para la Formulación de Cultivos Iniciadores de Masa Madre. Master’s Thesis, Instituto Tecnológico de Veracruz, Veracruz, México, 2023. [Google Scholar]
- Vázquez-Vázquez, M. Selección y Caracterización Fisiológica y Metabólica de Bacterias Ácido-Lácticas (BAL) Aisladas de la Fermentación de Café Para la Formulación de Cultivos Iniciadores. Master’s Thesis, Instituto Tecnológico de Veracruz, Veracruz, México, 2024. [Google Scholar]
- Jorquera, M.A.; Hernández, M.T.; Rengel, Z.; Marschner, P.; De La Luz Mora, M. Isolation of culturable phosphobacteria with both phytate-mineralization and phosphate-solubilization activity from the rhizosphere of plants grown in a volcanic soil. Biol. Fertil. Soils 2008, 44, 1025–1034. [Google Scholar] [CrossRef]
- Hasan, M.M.; Marzan, L.W.; Hosna, A.; Hakim, A.; Azad, A.K. Optimization of some fermentation conditions for the production of extracellular amylases by using Chryseobacterium and Bacillus isolates from organic kitchen wastes. J. Genet. Eng. Biotechnol. 2017, 15, 59–68. [Google Scholar] [CrossRef]
- Kwon, Y.M.; Choi, H.S.; Lim, J.Y.; Jang, H.S.; Chung, D. Characterization of amylolytic activity by a marine-derived yeast Sporidiobolus pararoseus PH-Gra1. Mycobiology 2020, 48, 195–203. [Google Scholar] [CrossRef]
- Ahi, M.; Hatamipour, M.S.; Goodarzi, A. Optimization of leavening activity of baker’s yeast during the spray-drying process. Drying Technol. 2010, 28, 490–494. [Google Scholar] [CrossRef]
- Borzani, W. Measurement of the gassing power of bakers’ yeast: Correlation between the dough volume and the incubation time. Braz. Arch. Biol. Technol. 2004, 47, 213–217. [Google Scholar] [CrossRef]
- Borshchevskaya, L.N.; Gordeeva, T.L.; Kalinina, A.N.; Sineokii, S.P. Spectrophotometric determination of lactic acid. J. Anal. Chem. 2016, 71, 755–758. [Google Scholar] [CrossRef]
- Menezes, L.A.A.; De Marco, I.; Oliveira dos Santos, N.N.; Costa Nunes, C.; Leite Cartabiano, C.E.; Molognoni, L.; Pereira, G.V.M.; Daguer, H.; De Dea Lindner, J. Reducing FODMAPs and improving bread quality using type II sourdough with selected starter cultures. Int. J. Food Sci. Nutr. 2021, 72, 912–922. [Google Scholar] [CrossRef]
- Ramon-Simon, X. Técnicas de Panadería con Masa Madre, Online course. Available online: https://www.scoolinary.com/es/courses/tecnicas-panaderia-masa-madre (accessed on 19 December 2022).
- Gonzales-Barron, U.; Butler, F. A comparison of seven thresholding techniques with the K-means clustering algorithm for measurement of bread-crumb features by digital image analysis. J. Food Eng. 2006, 74, 268–278. [Google Scholar] [CrossRef]
- Scheuer, P.M.; Ferreira, J.A.S.; Mattioni, B.; de Miranda, M.Z.; de Francisco, A. Optimization of image analysis techniques for quality assessment of whole-wheat breads made with fat replacer. Food Sci. Technol. 2015, 35, 133–142. [Google Scholar] [CrossRef]
- Rosales-Juárez, M.; González-Mendoza, B.; López-Guel, E.C.; Lozano-Bautista, F.; Chanona-Pérez, J.; Gutiérrez-López, G.; Farrera-Rebollo, R.; Calderón-Domínguez, G. Changes on dough rheological characteristics and bread quality as a result of the addition of germinated and non-germinated soybean flour. Food Bioproc. Technol. 2008, 1, 152–160. [Google Scholar] [CrossRef]
- López-Guel, E.C.; Lozano-Bautista, F.; Mora-Escobedo, R.; Farrera-Rebollo, R.R.; Chanona-Pérez, J.; Gutiérrez-López, G.F.; Calderón-Domínguez, G. Effect of soybean 7S protein fractions, obtained from germinated and nongerminated seeds, on dough rheological properties and bread quality. Food Bioproc. Technol. 2012, 5, 226–234. [Google Scholar] [CrossRef]
- Hayta, M.; Hendek Ertop, M. Evaluation of microtextural properties of sourdough wheat bread obtained from optimized formulation using scanning electron microscopy and image analysis during shelf life. J. Food Sci. Technol. 2018, 55, 3024–3031. [Google Scholar] [CrossRef]
- Aydın, F.; Günen, T.U.; Kahve, H.İ.; Güler, E.; Özer, G.; Aktepe, Y.; Çakır, İ. Molecular and technological characterization of Saccharomyces cerevisiae from sourdough. Fermentation 2023, 9, 329. [Google Scholar] [CrossRef]
- Martorana, A.; Giuffrè, A.M.; Capocasale, M.; Zappia, C.; Sidari, R. Sourdoughs as a source of lactic acid bacteria and yeasts with technological characteristics useful for improved bakery products. Eur. Food Res. Technol. 2018, 244, 1873–1885. [Google Scholar] [CrossRef]
- Guerzoni, M.E.; Serrazanetti, D.I.; Vernocchi, P.; Gianotti, A. Physiology and biochemistry of sourdough yeasts. In Handbook on Sourdough Biotechnology; Gobbetti, M., Gänzle, M., Eds.; Springer: Boston, MA, USA, 2013; pp. 155–181. ISBN 9781461454250. [Google Scholar] [CrossRef]
- Koçak, N.; Ardiç, M. Isolation, molecular characterization, and population analysis of Saccharomyces cerevisiae from sourdough collected from different provinces. Gıda 2024, 49, 179–192. [Google Scholar] [CrossRef]
- Lahue, C.; Madden, A.A.; Dunn, R.R.; Smukowski Heil, C. History and domestication of Saccharomyces cerevisiae in bread baking. Front. Genet. 2020, 11, 584718. [Google Scholar] [CrossRef]
- Leo, V.V.; Viswanath, V.; Deka, P.; Zothanpuia; Ramji, D.R.; Pachuau, L.; Carrie, W.; Malvi, Y.; Singh, G.; Singh, B.P. Saccharomyces and their potential applications in food and food processing industries. In Industrially Important Fungi for Sustainable Development; Springer: Cham, Switzerland, 2021; Volume 1, pp. 393–427. [Google Scholar] [CrossRef]
- Zhang, G.; Sun, Y.; Sadiq, F.A.; Sakandar, H.A.; He, G. Evaluation of the effect of Saccharomyces cerevisiae on fermentation characteristics and volatile compounds of sourdough. J. Food Sci. Technol. 2018, 55, 2079–2086. [Google Scholar] [CrossRef]
- Yang, H.; Sadiq, F.A.; Liu, T.; Zhang, G.; He, G. Use of physiological and transcriptome analysis to infer the interactions between Saccharomyces cerevisiae and Lactobacillus sanfranciscensis isolated from Chinese traditional sourdoughs. LWT 2020, 126, 109268. [Google Scholar] [CrossRef]
- Sieuwerts, S.; Bron, P.A.; Smid, E.J. Mutually stimulating interactions between lactic acid bacteria and Saccharomyces cerevisiae in sourdough fermentation. LWT 2018, 90, 201–206. [Google Scholar] [CrossRef]
- Korcari, D.; Ricci, G.; Capusoni, C.; Fortina, M.G. Physiological performance of Kazachstania unispora in sourdough environments. World J. Microbiol. Biotechnol. 2021, 37, 114. [Google Scholar] [CrossRef]
- De Vuyst, L.; Van Kerrebroeck, S.; Harth, H.; Huys, G.; Daniel, H.M.; Weckx, S. Microbial ecology of sourdough fermentations: Diverse or uniform? Food Microbiol. 2014, 37, 11–29. [Google Scholar] [CrossRef]
- Lancetti, R.; Sciarini, L.; Pérez, G.T.; Salvucci, E. Technological performance and selection of lactic acid bacteria isolated from Argentinian grains as starters for wheat sourdough. Curr. Microbiol. 2021, 78, 255–264. [Google Scholar] [CrossRef]
- Liu, T.; Li, Y.; Zhao, M.; Mo, Q.; Feng, F. Weight-reducing effect of Lactobacillus plantarum ZJUFT17 isolated from sourdough ecosystem. Nutrients 2020, 12, 977. [Google Scholar] [CrossRef]
- Tolu, V.; Fraumene, C.; Carboni, A.; Loddo, A.; Sanna, M.; Fois, S.; Roggio, T.; Catzeddu, P. Dynamics of microbiota in three backslopped liquid sourdoughs that were triggered with the same starter strains. Fermentation 2022, 8, 571. [Google Scholar] [CrossRef]
- Minervini, F.; Lattanzi, A.; De Angelis, M.; Di Cagno, R.; Gobbetti, M. Influence of artisan bakery- or laboratory-propagated sourdoughs on the diversity of lactic acid bacterium and yeast microbiotas. Appl. Environ. Microbiol. 2012, 78, 5328–5340. [Google Scholar] [CrossRef]
- Scheirlinck, I.; Van Der Meulen, R.; Van Schoor, A.; Vancanneyt, M.; De Vuyst, L.; Vandamme, P.; Huys, G. Influence of geographical origin and flour type on diversity of lactic acid bacteria in traditional Belgian sourdoughs. Appl. Environ. Microbiol. 2007, 73, 6262–6269. [Google Scholar] [CrossRef]
- Scheirlinck, I.; Van Der Meulen, R.; De Vuyst, L.; Vandamme, P.; Huys, G. Molecular source tracking of predominant lactic acid bacteria in traditional Belgian sourdoughs and their production environments. J. Appl. Microbiol. 2009, 106, 1081–1092. [Google Scholar] [CrossRef]
- Manini, F.; Casiraghi, M.C.; Poutanen, K.; Brasca, M.; Erba, D.; Plumed-Ferrer, C. Characterization of lactic acid bacteria isolated from wheat bran sourdough. LWT 2016, 66, 275–283. [Google Scholar] [CrossRef]
- Zotta, T.; Piraino, P.; Parente, E.; Salzano, G.; Ricciardi, A. Characterization of lactic acid bacteria isolated from sourdoughs for Cornetto, a traditional bread produced in Basilicata (southern Italy). World J. Microbiol. Biotechnol. 2008, 24, 1785–1795. [Google Scholar] [CrossRef]
- Bi, Q.; Hong, T.; Mei, X.; Xu, X.; Xu, D. Effect of high-molecular weight dextran-enriched sourdough fermented using Leuconostoc mesenteroides ATCC 8293 on bread quality and gluten. Food Biosci. 2023, 53, 102777. [Google Scholar] [CrossRef]
- Gumustop, I.; Ortakci, F. Analyzing the genetic diversity and biotechnological potential of Leuconostoc pseudomesenteroides by comparative genomics. Front. Microbiol. 2023, 13, 1074366. [Google Scholar] [CrossRef]
- Deckardt, K.; Khiaosa-Ard, R.; Grausgruber, H.; Zebeli, Q. Evaluation of various chemical and thermal feed processing methods for their potential to enhance resistant starch content in barley grain. Starch/Stärke 2014, 66, 558–565. [Google Scholar] [CrossRef]
- Majzoobi, M.; Beparva, P. Effects of acetic acid and lactic acid on physicochemical characteristics of native and cross-linked wheat starches. Food Chem. 2014, 147, 312–317. [Google Scholar] [CrossRef]
- Majzoobi, M.; Radi, M.; Farahnaky, A.; Tongdang, T. Effects of L-ascorbic acid on physicochemical characteristics of wheat starch. J. Food Sci. 2012, 77, C258–C264. [Google Scholar] [CrossRef]
- Wang, Z.; Wang, L. Impact of sourdough fermentation on nutrient transformations in cereal-based foods: Mechanisms, practical applications, and health implications. Grain Oil Sci. Technol. 2024, 7, 124–132. [Google Scholar] [CrossRef]
- Sun, L.; Sun, X.; Du, Y.; Fang, Y.; Yang, W.; Hu, Q.; Pei, F. Effect of the starch structure fermented by Lactobacillus plantarum LB-1 and yeast on rheological and thermomechanical characteristics of dough. Food Chem. 2022, 369, 130877. [Google Scholar] [CrossRef]
- David, I.; Mişcă, C.; Bujancă, G.; Rinovetz, A.; Danci, M. The monitoring of enzyme activity of glucoamylase and endoxylanase on the bread dough with consitographic method. J. Agroaliment. Processes Technol. 2023, 19, 338–343. [Google Scholar]
- David, I.; Danci, M.; Chiş-Junior, S. The consistographic determinations of different types of amylase on the bread dough. J. Hortic. For. Biotechnol. 2014, 18, 203–207. [Google Scholar]
- Lee, J.Y.; Im, Y.K.; Chin, J.E.; Bai, S. Construction of amylolytic yeasts secreting xylanase and phytase to improve bread quality. Korean J. Microbiol. 2020, 56, 170–176. [Google Scholar] [CrossRef]
- Chiravi, K.; Khan, M.A.; Wadikar, D.D.; Mahesh, C.; Semwal, A.D. Starch retrogradation: Role of food ingredients and extrinsic factors. Food Sci. Eng. 2023, 4, 204–215. [Google Scholar] [CrossRef]
- Palacios, H.R.; Schwarz, P.B.; D’Appolonia, B.L. Effect of α-amylases from different sources on the retrogradation and recrystallization of concentrated wheat starch gels: Relationship to bread staling. J. Agric. Food Chem. 2004, 52, 5978–5986. [Google Scholar] [CrossRef]
- Wang, S.; Li, C.; Copeland, L.; Niu, Q.; Wang, S. Starch retrogradation: A comprehensive review. Compr. Rev. Food Sci. Food Saf. 2015, 14, 568–585. [Google Scholar] [CrossRef]
- Laluce, C.; Bertolini, M.C.; Ernandes, J.R.; Martini, A.V.; Martini, A. New amylolytic yeast strains for starch and dextrin fermentation. Appl. Environ. Microbiol. 1988, 54, 2447–2451. [Google Scholar] [CrossRef]
- Akamine, I.T.; Mansoldo, F.R.P.; Cardoso, V.S.; de Souza Dias, E.P.; Vermelho, A.B. Hydrolase activities of sourdough microorganisms. Fermentation 2023, 9, 703. [Google Scholar] [CrossRef]
- Palla, M.; Cristani, C.; Giovannetti, M.; Agnolucci, M. Identification and characterization of lactic acid bacteria and yeasts of PDO Tuscan bread sourdough by culture dependent and independent methods. Int. J. Food Microbiol. 2017, 250, 19–26. [Google Scholar] [CrossRef]
- Damayanti, E.; Ichsyani, M.; Istiqomah, L.; Anggraeni, A.S.; Kurniadi, M. Fermentation of amylolytic yeast and lactic acid bacteria to improve the quality of modified cassava. IOP Conf. Ser. Mater. Sci. Eng. 2021, 1011, 012004. [Google Scholar] [CrossRef]
- Díaz-Ruiz, G.; Guyot, J.P.; Ruiz-Teran, F.; Morlon-Guyot, J.; Wacher, C. Microbial and physiological characterization of weakly amylolytic but fast-growing lactic acid bacteria: A functional role in supporting microbial diversity in pozol, a Mexican fermented maize beverage. Appl. Environ. Microbiol. 2003, 69, 4367–4374. [Google Scholar] [CrossRef]
- Amapu, T.; Ameh, J.; Ado, S.; Abdullahi, I.; Dapiya, H. Amylolytic potential of lactic acid bacteria isolated from wet milled cereals, cassava flour and fruits. Br. Microbiol. Res. J. 2016, 13, 1–8. [Google Scholar] [CrossRef]
- Elida, M.; Agustina, A.; Ermiati, E.; Desminarti, S. Isolate characterization and amylolytic properties of lactic acid bacteria from traditional fermented dadih. IOP Conf. Ser. Earth Environ. Sci. 2022, 1097, 012025. [Google Scholar] [CrossRef]
- Gopinath, S.C.B.; Anbu, P.; Arshad, M.K.M.; Lakshmipriya, T.; Voon, C.H.; Hashim, U.; Chinni, S.V. Biotechnological processes in microbial amylase production. Biomed. Res. Int. 2017, 2017, 1272193. [Google Scholar] [CrossRef]
- Huang, X.; Schuppan, D.; Tovar, L.E.R.; Zevallos, V.F.; Loponen, J.; Gänzle, M. Sourdough fermentation degrades wheat alpha-amylase/trypsin inhibitor (ATI) and reduces pro-inflammatory activity. Foods 2020, 9, 943. [Google Scholar] [CrossRef]
- Zotta, T.; Piraino, P.; Ricciardi, A.; McSweeney, P.L.H.; Parente, E. Proteolysis in model sourdough fermentations. J. Agric. Food Chem. 2006, 54, 2567–2574. [Google Scholar] [CrossRef]
- Rizzello, C.G.; De Angelis, M.; Coda, R.; Gobbetti, M. Use of selected sourdough lactic acid bacteria to hydrolyze wheat and rye proteins responsible for cereal allergy. Eur. Food Res. Technol. 2006, 223, 405–411. [Google Scholar] [CrossRef]
- Pérez-Alvarado, O.; Zepeda-Hernández, A.; Garcia-Amezquita, L.E.; Requena, T.; Vinderola, G.; García-Cayuela, T. Role of lactic acid bacteria and yeasts in sourdough fermentation during breadmaking: Evaluation of postbiotic-like components and health benefits. Front. Microbiol. 2022, 13, 969460. [Google Scholar] [CrossRef] [PubMed]
- Nutter, J.; Saiz, A.I.; Iurlina, M.O. Microstructural and conformational changes of gluten proteins in wheat-rye sourdough. J. Cereal Sci. 2019, 87, 91–97. [Google Scholar] [CrossRef]
- Nouska, C.; Hatzikamari, M.; Matsakidou, A.; Biliaderis, C.G.; Lazaridou, A. Enhancement of textural and sensory characteristics of wheat bread using a chickpea sourdough fermented with a selected autochthonous microorganism. Foods 2023, 12, 3112. [Google Scholar] [CrossRef]
- Ebrahimi, M.; Sadeghi, A.; Mortazavi, S.A. The use of cyclic dipeptide producing LAB with potent anti-aflatoxigenic capability to improve techno-functional properties of clean-label bread. Ann. Microbiol. 2020, 70, 24. [Google Scholar] [CrossRef]
- Muskovics, G.; Farkas, A.; Bugyi, Z.; Tömösközi, S. Changes of gluten protein composition during sourdough fermentation in rye flour. Cereal Chem. 2024, 101, e10837. [Google Scholar] [CrossRef]
- Hernández-Figueroa, R.H.; Mani-López, E.; Palou, E.; López-Malo, A. Sourdoughs as natural enhancers of bread quality and shelf life: A review. Fermentation 2024, 10, 7. [Google Scholar] [CrossRef]
- Syrokou, M.K.; Tziompra, S.; Psychogiou, E.E.; Mpisti, S.D.; Paramithiotis, S.; Bosnea, L.; Mataragas, M.; Skandamis, P.N.; Drosinos, E.H. Technological and safety attributes of lactic acid bacteria and yeasts isolated from spontaneously fermented Greek wheat sourdoughs. Microorganisms 2021, 9, 671. [Google Scholar] [CrossRef]
- Prasev, I.; Denkova-Kostova, R.; Koleva, A.; Denkova, Z.; Goranov, B.; Dobrev, I.; Kostov, G. Examination of some technological properties of lactic acid bacteria of the genera Lactiplantibacillus and Levilactobacillus isolated from spontaneously fermented sourdough. Part 1: Enzymatic profile. BIO Web Conf. 2025, 70, 02003. [Google Scholar] [CrossRef]
- Sukmawati, D.; Al Husna, S.N.; Saszieta, D.; Priskaningrum, A.M.; Mutiani, A.M.; Sari, A.B.T.; El-Enshasy, H.A. Screening and isolation of indigenous cellulolytic and proteolytic yeasts from fermented dried cocoa beans. AIP Conf. Proc. 2024, 2896, 050019. [Google Scholar] [CrossRef]
- Rodarte, M.P.; Dias, D.R.; Vilela, D.M.; Schwan, R.F. Atividade proteolítica de bactérias, leveduras e fungos filamentosos presentes em grãos de café (Coffea arabica L.). Acta Sci. Agron. 2011, 33, 457–464. [Google Scholar] [CrossRef]
- Muzaifa, M.; Nilda, C.; Rahmi, F. Identification of proteolytic and pectinolytic yeasts from civet (Paradoxorus hermaphroditus) and evaluation of their potential to modify coffee bean quality. J. Agric. Sci. Technol. 2023, 13, 85–95. [Google Scholar] [CrossRef]
- Mohammadi-Kouchesfahani, M.; Hamidi-Esfahani, Z.; Azizi, M.H. Isolation and identification of lactic acid bacteria with phytase activity from sourdough. Food Sci. Nutr. 2019, 7, 3700–3708. [Google Scholar] [CrossRef]
- Palla, M.; Blandino, M.; Grassi, A.; Giordano, D.; Sgherri, C.; Quartacci, M.F.; Reyneri, A.; Agnolucci, M.; Giovannetti, M. Characterization and selection of functional yeast strains during sourdough fermentation of different cereal wholegrain flours. Sci. Rep. 2020, 10, 14629. [Google Scholar] [CrossRef]
- Fekri, A.; Torbati, M.; Yari Khosrowshahi, A.; Bagherpour Shamloo, H.; Azadmard-Damirchi, S. Functional effects of phytate-degrading, probiotic lactic acid bacteria and yeast strains isolated from Iranian traditional sourdough on the technological and nutritional properties of whole wheat bread. Food Chem. 2020, 306, 125620. [Google Scholar] [CrossRef]
- Rizzello, C.G.; Coda, R.; Gobbetti, M. Use of sourdough fermentation and nonwheat flours for enhancing nutritional and healthy properties of wheat-based foods. In Flour and Breads and Their Fortification in Health and Disease Prevention, 2nd ed.; Elsevier Inc.: London, UK, 2017; pp. 219–228. ISBN 9780128023099. [Google Scholar] [CrossRef]
- Gobbetti, M.; De Angelis, M.; Di Cagno, R.; Calasso, M.; Archetti, G.; Rizzello, C.G. Novel insights on the functional/nutritional features of the sourdough fermentation. Int. J. Food Microbiol. 2019, 302, 103–113. [Google Scholar] [CrossRef]
- Sergeeva, A.; Novichenko, A.; Ivanova, V.; Gurev, S.; Korovyansky, V. Evaluation of breadmaking potential of the yeasts Wickerhamomyces anomalus (CBS S605T) and Torulaspora delbrueckii (YIT3). E3S Web of Conf. 2024, 539, 02033. [Google Scholar] [CrossRef]
- Walker, G.M. Pichia anomala: Cell physiology and biotechnology relative to other yeasts. Antonie Van Leeuwenhoek 2011, 99, 25–34. [Google Scholar] [CrossRef]
- Schwentke, J.; Sabel, A.; Petri, A.; König, H.; Claus, H. The yeast Wickerhamomyces anomalus AS1 secretes a multifunctional exo-β-1,3-glucanase with implications for winemaking. Yeast 2014, 31, 349–359. [Google Scholar] [CrossRef]
- López-Enríquez, L.; Vila-Crespo, J.; Rodríguez-Nogales, J.M.; Fernández-Fernández, E.; Ruipérez, V. Modulation of the aromatic profile of Verdejo wine through sequential inoculation of Wickerhamomyces anomalus and Saccharomyces cerevisiae. Fermentation 2023, 9, 977. [Google Scholar] [CrossRef]
- Sánchez-Adriá, I.E.; Sanmartín, G.; Prieto, J.A.; Estruch, F.; Fortis, E.; Randez-Gil, F. Technological and acid stress performance of yeast isolates from industrial sourdough. LWT 2023, 184, 114957. [Google Scholar] [CrossRef]
- Woo, S.H.; Park, J.; Sung, J.M.; Choi, E.J.; Choi, Y.S.; Park, J.D. Characterization of lactic acid bacteria and yeast from grains as starter cultures for gluten-free sourdough. Foods 2023, 12, 4367. [Google Scholar] [CrossRef]
- Ferraz, R.; Flores, S.H.; Frazzon, J.; Thys, R.C.S. The effect of co-fermentation on sourdough breadmaking using different viable cell concentrations of Lactobacillus plantarum and Saccharomyces cerevisiae as starter cultures. J. Culin. Sci. Technol. 2021, 19, 1–17. [Google Scholar] [CrossRef]
- Romanens, E.; Freimüller Leischtfeld, S.; Volland, A.; Stevens, M.; Krähenmann, U.; Isele, D.; Fischer, B.; Meile, L.; Miescher Schwenninger, S. Screening of lactic acid bacteria and yeast strains to select adapted anti-fungal co-cultures for cocoa bean fermentation. Int. J. Food Microbiol. 2019, 290, 262–272. [Google Scholar] [CrossRef]
- Samagaci, L.; Ouattara, H.G.; Goualié, B.G.; Niamke, S.L. Growth capacity of yeasts potential starter strains under cocoa fermentation stress conditions in Ivory Coast. Emir. J. Food Agric. 2014, 26, 861–870. [Google Scholar] [CrossRef]
- Pereira, G.V.M.; Miguel, M.G.C.P.; Ramos, C.L.; Schwan, R.F. Microbiological and physicochemical characterization of small-scale cocoa fermentations and screening of yeast and bacterial strains to develop a defined starter culture. Appl. Environ. Microbiol. 2012, 78, 5395–5405. [Google Scholar] [CrossRef]
- Elhariry, H.M.; Mahmoud, R.M.; Hassan, A.A.; Aly, M.A. Development of co-culture sourdough systems for improving bread quality and delaying staling. Food Biotechnol. 2011, 25, 252–272. [Google Scholar] [CrossRef]
- Coda, R.; Di Cagno, R.; Gobbetti, M.; Rizzello, C.G. Sourdough lactic acid bacteria: Exploration of non-wheat cereal-based fermentation. Food Microbiol. 2014, 37, 51–58. [Google Scholar] [CrossRef]
- De Angelis, M.; Gobbetti, M. Environmental stress responses in Lactobacillus: A review. Proteomics 2004, 4, 106–122. [Google Scholar] [CrossRef]
- Gänzle, M.; Gobbetti, M. Physiology and biochemistry of lactic acid bacteria. In Handbook on Sourdough Biotechnology; Springer: Boston, MA, USA, 2013; pp. 183–216. ISBN 9781461454250. [Google Scholar] [CrossRef]
- Wu, Y.; Yu, M.; Li, Y.; Zhu, S.; Huang, D. The synergistic effect of lactic acid bacteria fermentation combined with gluten on the starch digestive properties of highland barley. Food Biosci. 2024, 58, 103822. [Google Scholar] [CrossRef]
- Settanni, L.; Ventimiglia, G.; Alfonzo, A.; Corona, O.; Miceli, A.; Moschetti, G. An integrated technological approach to the selection of lactic acid bacteria of flour origin for sourdough production. Food Res. Int. 2013, 54, 1569–1578. [Google Scholar] [CrossRef]
- Wang, S.; Copeland, L. Effect of acid hydrolysis on starch structure and functionality: A review. Crit. Rev. Food Sci. Nutr. 2015, 55, 1081–1097. [Google Scholar] [CrossRef]
- Zhang, M.; Jia, H.; Wang, B.; Ma, C.; He, F.; Fan, Q.; Liu, W. A prospective review on the research progress of citric acid modified starch. Foods 2023, 12, 458. [Google Scholar] [CrossRef]
- Ulbrich, M.; Natan, C.; Flöter, E. Acid modification of wheat, potato, and pea starch applying gentle conditions—Impacts on starch properties. Starch/Stärke 2014, 66, 903–913. [Google Scholar] [CrossRef]
- Shao, D.; Zhang, J.; Shao, T.; Li, Y.; He, H.; Wang, Y.; Ma, J.; Cao, R.; Li, A.; Du, X. Modification of structure, pasting, and in vitro digestion properties of glutinous rice starch by different lactic acid bacteria fermentation. Foods 2025, 14, 367. [Google Scholar] [CrossRef]
- Mou, T.; Xu, R.; Li, Q.; Li, J.; Liu, S.; Ao, X.; Chen, S.; Liu, A. Screening of antifungal lactic acid bacteria and their impact on the quality and shelf life of rye bran sourdough bread. Foods 2025, 14, 1253. [Google Scholar] [CrossRef]
- Li, M.; Zhang, H.; Lyu, L.; Deng, Q.; Fan, H.; Xu, X.; Xu, D. Effects of sourdough on bread staling rate: From the perspective of starch retrogradation and gluten depolymerization. Food Biosci. 2024, 59, 103877. [Google Scholar] [CrossRef]
- Zhang, T.; Hong, S.; Zhang, J.R.; Liu, P.H.; Li, S.; Wen, Z.; Xiao, J.; Zhang, G.; Habimana, O.; Shah, N.P.; et al. The effect of lactic acid bacteria fermentation on physicochemical properties of starch from fermented proso millet flour. Food Chem. 2024, 437, 137764. [Google Scholar] [CrossRef]
- Ventimiglia, G.; Alfonzo, A.; Galluzzo, P.; Corona, O.; Francesca, N.; Caracappa, S.; Moschetti, G.; Settanni, L. Codominance of Lactobacillus plantarum and obligate heterofermentative lactic acid bacteria during sourdough fermentation. Food Microbiol. 2015, 51, 57–68. [Google Scholar] [CrossRef]
- Di Monaco, R.; Torrieri, E.; Pepe, O.; Masi, P.; Cavella, S. Effect of sourdough with exopolysaccharide (EPS)-producing lactic acid bacteria (LAB) on sensory quality of bread during shelf life. Food Bioprocess Technol. 2015, 8, 691–701. [Google Scholar] [CrossRef]
- Galle, S.; Arendt, E.K. Exopolysaccharides from sourdough lactic acid bacteria. Crit. Rev. Food Sci. Nutr. 2014, 54, 891–901. [Google Scholar] [CrossRef]
- Milanovic, V.; Osimani, A.; Garofalo, C.; Belleggia, L.; Maoloni, A.; Cardinali, F.; Mozzon, M.; Foligni, R.; Aquilanti, L.; Clementi, F. Selection of cereal-sourced lactic acid bacteria as candidate starters for the baking industry. PLoS ONE 2020, 15, e0236190. [Google Scholar] [CrossRef]
- Tieking, M.; Korakli, M.; Ehrmann, M.A.; Gänzle, M.G.; Vogel, R.F. In situ production of exopolysaccharides during sourdough fermentation by cereal and intestinal isolates of lactic acid bacteria. Appl. Environ. Microbiol. 2003, 69, 945–952. [Google Scholar] [CrossRef]
- Valerio, F.; Bavaro, A.R.; Di Biase, M.; Lonigro, S.L.; Logrieco, A.F.; Lavermicocca, P. Effect of amaranth and quinoa flours on exopolysaccharide production and protein profile of liquid sourdough fermented by Weissella cibaria and Lactobacillus plantarum. Front. Microbiol. 2020, 11, 967. [Google Scholar] [CrossRef]
- Sha, H.Y.; Wang, Q.Q.; Li, Z.J. Comparison of the effect of exopolysaccharide-producing lactic acid bacteria from sourdough on dough characteristics and steamed bread quality. Int. J. Food Sci. Technol. 2023, 58, 378–386. [Google Scholar] [CrossRef]
- Dertli, E.; Mercan, E.; Arici, M.; Yilmaz, M.T.; Sağdiç, O. Characterisation of lactic acid bacteria from Turkish sourdough and determination of their exopolysaccharide (EPS) production characteristics. LWT 2016, 71, 116–124. [Google Scholar] [CrossRef]
- Xu, D.; Hu, Y.; Wu, F.; Jin, Y.; Xu, X.; Gänzle, M.G. Comparison of the functionality of exopolysaccharides produced by sourdough lactic acid bacteria in bread and steamed bread. J. Agric. Food Chem. 2020, 68, 8907–8914. [Google Scholar] [CrossRef]
- Agbo, B.E.; Edeghor, U.; Lennox, J.; Aminadokiari, D. Bread fermentation using synergistic activity between lactic acid bacteria (Lactobacillus bulgaricus) and baker’s yeast (Saccharomyces cerevisiae). Int. J. Curr. Microbiol. App. Sci. 2016, 5, 26–34. [Google Scholar]
- Wang, Z.; Yan, J.; Ma, S.; Tian, X.; Sun, B.; Huang, J.; Li, L.; Wang, X.; Bao, Q. Effect of wheat bran dietary fiber on structural properties of wheat starch after synergistic fermentation of Lactobacillus plantarum and Saccharomyces cerevisiae. Int. J. Biol. Macromol. 2021, 190, 86–92. [Google Scholar] [CrossRef]
- Ponomarova, O.; Gabrielli, N.; Sévin, D.C.; Mülleder, M.; Zirngibl, K.; Bulyha, K.; Andrejev, S.; Kafkia, E.; Typas, A.; Sauer, U.; et al. Yeast creates a niche for symbiotic lactic acid bacteria through nitrogen overflow. Cell Syst. 2017, 5, 345–357.e6. [Google Scholar] [CrossRef]
- Canon, F.; Nidelet, T.; Guédon, E.; Thierry, A.; Gagnaire, V. Understanding the mechanisms of positive microbial interactions that benefit lactic acid bacteria co-cultures. Front. Microbiol. 2020, 11, 575580. [Google Scholar] [CrossRef]
- Sun, X.; Wu, S.; Li, W.; Koksel, F.; Du, Y.; Sun, L.; Fang, Y.; Hu, Q.; Pei, F. The effects of cooperative fermentation by yeast and lactic acid bacteria on the dough rheology, retention and stabilization of gas cells in a whole wheat flour dough system—A review. Food Hydrocoll. 2023, 135, 108155. [Google Scholar] [CrossRef]
- Carbonetto, B.; Nidelet, T.; Guezenec, S.; Perez, M.; Segond, D.; Sicard, D. Interactions between Kazachstania humilis yeast species and lactic acid bacteria in sourdough. Microorganisms 2020, 8, 240. [Google Scholar] [CrossRef]
- Zghal, M.C.; Scanlon, M.G.; Sapirstein, H.D. Prediction of bread crumb density by digital image analysis. Cereal Chem. 1999, 76, 734–742. [Google Scholar] [CrossRef]
- Shibata, M.; Tsuta, M.; Sugiyama, J.; Fujita, K.; Kokawa, M.; Araki, T.; Nabetani, H. Image analysis of bread crumb structure in relation to mechanical properties. Int. J. Food Eng. 2013, 9, 115–120. [Google Scholar] [CrossRef]
- Onipe, O.O.; Beswa, D.; Jideani, A.I.O. Confocal laser scanning microscopy and image analysis for elucidating crumb and crust microstructure of bran-enriched South African fried dough and batter. Foods 2020, 9, 605. [Google Scholar] [CrossRef]
- Peñaloza-Espinosa, J.; De, G.J.; Rosa-Angulo, L.; Mora-Escobedo, R.; Chanona-Pérez, J.; Farrera-Rebollo, R.; Calderón-Domínguez, G. Sourdough and bread properties as affected by soybean protein addition. In Soybean—Applications and Technology; Ng, T.-B., Ed.; IntechOpen: London, UK, 2011. [Google Scholar] [CrossRef]
- Dos Santos, J.G.; de Ávila, P.M.; Borges Gomes, R.A.; de Souza Monteiro, R.; Vieira, S.M.; Pimenta Pereira, P.A. Use of natural yogurt, pineapple juice, and beer wort as starter cultures in sourdough combined with white and whole wheat flours to improve the technological characteristics of milk breads. MOJ Food Process. Technol. 2023, 11, 9–14. [Google Scholar] [CrossRef]
- Scheuer, P.M.; Southgate, A.N.N.; Martelli, M.F.; Dias, C.; da Silva, M.E.; Coelho, A.A.; de Francisco, A. Quality properties of a bread made with levain and cocoa waste. J. Culin. Sci. Technol. 2022, 20, 409–420. [Google Scholar] [CrossRef]
- Hu, Y.; Zhang, J.; Wang, S.; Liu, Y.; Li, L.; Gao, M. Lactic acid bacteria synergistic fermentation affects the flavor and texture of bread. J. Food Sci. 2022, 87, 1823–1836. [Google Scholar] [CrossRef]






| Identification Method | Microorganism | Length (bp) | Match/Total (bp) | Identity (%) |
|---|---|---|---|---|
| ITS region | Saccharomyces cerevisiae YCTA5 | 850 | 841/842 | 99.9 |
| ITS region | Saccharomyces cerevisiae YCTA9 | 832 | 832/832 | 100 |
| ITS region | Saccharomyces cerevisiae YCTA10 | 833 | 832/832 | 100 |
| ITS region | Saccharomyces cerevisiae YCTA12 | 828 | 823/823 | 100 |
| ITS region | Saccharomyces cerevisiae YCTA13 | 834 | 833/833 | 100 |
| ITS region | Saccharomyces cerevisiae YCTA14 | 849 | 833/835 | 99.8 |
| ITS region | Saccharomyces cerevisiae YCTA15 | 848 | 834/834 | 100 |
| ITS region | Saccharomyces cerevisiae YCTA16 | 844 | 827/827 | 100 |
| 16S rDNA | Lactiplantibacillus pentosus LABCTA1 | 1246 | 691/695 | 99.4 |
| 16S rDNA | Leuconostoc mesenteroides LABCTA3 | 912 | 886/891 | 99.4 |
| 16S rDNA | Lactiplantibacillus plantarum LABCTA6 | 1427 | 680/683 | 99.6 |
| 16S rDNA | Lactiplantibacillus plantarum LABCTA8 | 1593 | 673/679 | 99.1 |
| Halo Diameter (mm) | ||||
|---|---|---|---|---|
| Strain | Amylolytic Activity | Proteolytic Activity | Phytasic Activity | Reference |
| Yeast | ||||
| S. cerevisiae YCTA5 | 1.36 ± 0.04 ab | 34.15 ± 1.16 bc | 16.05 ± 1.19 a | This study |
| S. cerevisiae YCTA9 | 1.43 ± 0.03 a | 38.31 ± 1.15 a | 15.85 ± 0.41 a | This study |
| S. cerevisiae YCTA10 | 1.28 ± 0.03 b | 36.51 ± 1.83 ab | 14.94 ± 1.04 a | This study |
| S. cerevisiae YCTA12 | 1.37 ± 0.02 ab | 37.78 ± 0.33 ab | 14.68 ± 0.24 a | This study |
| S. cerevisiae YCTA13 | 1.39 ± 0.05 ab | 31.98 ± 1.16 c | 14.33 ± 0.21 a | This study |
| S. cerevisiae YCTA14 | 1.37 ± 0.05 ab | 39.86 ± 0.35 b | 14.21 ± 0.66 a | This study |
| S. cerevisiae YCTA15 | 1.37 ± 0.06 ab | 15.97 ± 0.07 d | 15.48 ± 0.38 a | This study |
| S. cerevisiae YCTA16 | 1.40 ± 0.01 ab | 36.26 ± 0.41 ab | 13.73 ± 0.31 a | This study |
| W. anomalus YX1SR15 | 24.92 ± 0.02 ab | 25.08 ± 0.02 ab | 17.51 ± 0.11 ab | [32] * |
| W. anomalus YX1SR23 | 20.04 ± 0.02 ab | 27.40 ± 0.04 ab | 15.82 ± 0.06 ab | [32] * |
| LAB | ||||
| Lpb. pentosus LABCTA1 | 0.80 ± 0.01 B | 27.80 ± 0.67 B | 36.89 ± 2.14 B | This study |
| Leu. mesenteroides LABCTA3 | 0.90 ± 0.01 A | 40.00 ± 0.00 A | 32.75 ± 0.04 B | This study |
| Lpb. plantarum LABCTA6 | 0.81 ± 0.03 B | 15.78 ± 1.09 C | 48.48 ± 0.61 A | This study |
| Lpb. plantarum LABCTA8 | 0.86 ± 0.01 AB | 24.15 ± 1.31 B | 46.00 ± 0.08 A | This study |
| Lpb. plantarum LAB20B3HB | 0.20 ± 0.01 ab | 29.47 ± 0.31 ab | 22.00 ± 0.08 ab | [33] ** |
| Bacteria Strain | EPS Production | Reference | Leu. mesenteroides LABCTA3 |
|---|---|---|---|
| Lpb. pentosus LABCTA1 | - | This work | |
| Leu. mesenteroides LABCTA3 | + | This work | |
| Lpb. plantarum LABCTA6 | - | This work | |
| Lpb. plantarum LABCTA8 | - | This work | |
| Lpb. plantarum 20B3HB | + | Vazquez-Vazquez [33] ** |
| Starter Co-Culture | LAB Strain | Yeast Strain |
|---|---|---|
| B3Y5 | Leu. mesenteroides LABCTA3 | S. cerevisiae YCTA5 |
| B3Y13 | Leu. mesenteroides LABCTA3 | S. cerevisiae YCTA13 |
| B3Y14 | Leu. mesenteroides LABCTA3 | S. cerevisiae YCTA14 |
| B20Y5 | Lpb. plantarum 20B3HB | S. cerevisiae YCTA5 |
| B20Y13 | Lpb. plantarum 20B3HB | S. cerevisiae YCTA13 |
| B20Y14 | Lpb. plantarum 20B3HB | S. cerevisiae YCTA14 |
Disclaimer/Publisher’s Note: The statements, opinions and data contained in all publications are solely those of the individual author(s) and contributor(s) and not of MDPI and/or the editor(s). MDPI and/or the editor(s) disclaim responsibility for any injury to people or property resulting from any ideas, methods, instructions or products referred to in the content. |
© 2025 by the authors. Licensee MDPI, Basel, Switzerland. This article is an open access article distributed under the terms and conditions of the Creative Commons Attribution (CC BY) license (https://creativecommons.org/licenses/by/4.0/).
Share and Cite
Hernández-Parada, N.; Gutiérrez-Ríos, H.G.; Rayas-Duarte, P.; González-Ríos, O.; Suárez-Quiroz, M.L.; Hernández-Estrada, Z.J.; Figueroa-Espinoza, M.C.; Figueroa-Hernández, C.Y. Screening Sourdough Starter Cultures from Yeast and Lactic Acid Bacteria Isolated from Mexican Cocoa Mucilage and Coffee Pulp for Bread Quality Improvement. Fermentation 2025, 11, 498. https://doi.org/10.3390/fermentation11090498
Hernández-Parada N, Gutiérrez-Ríos HG, Rayas-Duarte P, González-Ríos O, Suárez-Quiroz ML, Hernández-Estrada ZJ, Figueroa-Espinoza MC, Figueroa-Hernández CY. Screening Sourdough Starter Cultures from Yeast and Lactic Acid Bacteria Isolated from Mexican Cocoa Mucilage and Coffee Pulp for Bread Quality Improvement. Fermentation. 2025; 11(9):498. https://doi.org/10.3390/fermentation11090498
Chicago/Turabian StyleHernández-Parada, Natali, Hugo Gabriel Gutiérrez-Ríos, Patricia Rayas-Duarte, Oscar González-Ríos, Mirna Leonor Suárez-Quiroz, Zorba Josué Hernández-Estrada, María Cruz Figueroa-Espinoza, and Claudia Yuritzi Figueroa-Hernández. 2025. "Screening Sourdough Starter Cultures from Yeast and Lactic Acid Bacteria Isolated from Mexican Cocoa Mucilage and Coffee Pulp for Bread Quality Improvement" Fermentation 11, no. 9: 498. https://doi.org/10.3390/fermentation11090498
APA StyleHernández-Parada, N., Gutiérrez-Ríos, H. G., Rayas-Duarte, P., González-Ríos, O., Suárez-Quiroz, M. L., Hernández-Estrada, Z. J., Figueroa-Espinoza, M. C., & Figueroa-Hernández, C. Y. (2025). Screening Sourdough Starter Cultures from Yeast and Lactic Acid Bacteria Isolated from Mexican Cocoa Mucilage and Coffee Pulp for Bread Quality Improvement. Fermentation, 11(9), 498. https://doi.org/10.3390/fermentation11090498








